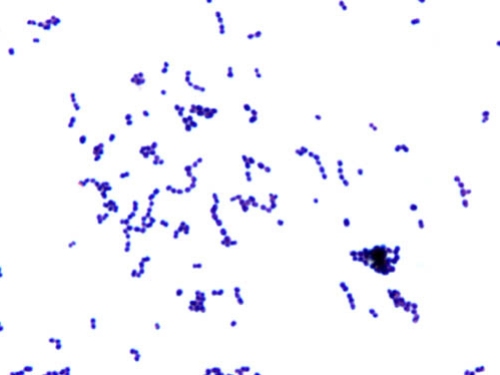

Gram Stain Examples
Click on the thumbnails below to view the full sized images
Gram stain control
Gram stain control
Taken from an SBA control plate, Gram negative rod (Escherichia coli) which is physically mixed with a Gram positive cocci (Enterococcus faecalis). A good control would be rated as having a strong purple color in the Gram positive cocci and strong red color in the Gram negative rods.

Gram stain control
Safranin crystals #1
Gram stain artifact
In addition to the Gram positive cocci, this Gram stain has residual safranin crystals. Note the thin red crystals, which are very long in the center of the image, to very small in the surrounding areas. The presence of safranin crystals are due to an inadequate rinse of the slide at the end of the Gram stain procedure.

Safranin crystals #1
Gram negative rod
Gram negative rod (Escherichia coli)
Note the pleomorphic rods (some long, some short). A general characteristic of E. coli, along with most enteric Gram negative rods, is that they do not form cellular arrangements such as clusters, chains, pairs, etc. The rod in the upper left corner shows uneven staining (might be hard to see) referred to as "bipolar" staining where the ends take up the stain darker and may be misinterpreted as a Gram negative diplococcus.
Gram stain report: 4+ G neg rod

Gram negative rod
Gram positive cocci/chains
Gram positive cocci/chains (Streptococcus pyogenes)
One characteristic of this species is the ability to chain as it is dividing. If an organism can chain, it should be noted in place of the other cellular arrangements. For example in this photo, in addition to the chains, there are some cluster and pairs, however, chains would be the cellular arrangement reported.
Gram stain report: 4+ G pos cocci/chains.
Gram positive cocci/chains
Gram positive cocci/chains
Gram positive cocci/chains (Streptococcus pyogenes)
This is a Gram stain taken from a blood culture - note the red blood cell "ghosts" in the background. In broth, such as blood culture, this organism will form long chains which is very characteristic of the species. On a culture plate, where there is less room, the organism will form shorter chains and the chains maybe less frequent.
The ghost red blood cells in this image have all popped during the Gram stain preparation. Occasionally, intact RBC's will be seen as large bright red circular cells.
Gram stain report: 4+ G pos cocci/chains

Gram positive cocci/chains
Gram positive diplococcus
Gram positive diplococcus (Streptococcus pneumoniae)
This is a blood culture. Notice the cocci in pairs which are described as a lancet shaped (slightly drawn out at the ends), which is a hallmark of this species. Almost all the cells are paired. The term "G pos diplococcus" is reserved for one specific species only, which is S. pneumoniae. If you are uncertain, you can report G pos cocci/pairs.
Gram stain report: 4+ G pos diplococcus

Gram positive diplococcus
Gram neg rod with bipolar staining
Bipolar staining
This is an example of a Gram neg rod that has taken up the safranin stain in an uneven pattern, called bipolar staining. The center of the cell is lighter and the ends are darker. This can often be confused as a Gram negative diplococcus.
Gram stain report: 4+ G neg rods

Gram neg rod with bipolar staining
Gram pos cocci
This is an example of a Gram pos cocci (Staphylococcus epidermidis)
This photo demonstrates almost all arrangements - pairs, clusters, tetrads, singles, and even a chain or two. Since there is no real majority, a cellular arrangement would not reported. Also, the occurrence of one or two chains is probably by chance as the cells were being spread onto the slide.
Gram stain report: 4+ G pos cocci



